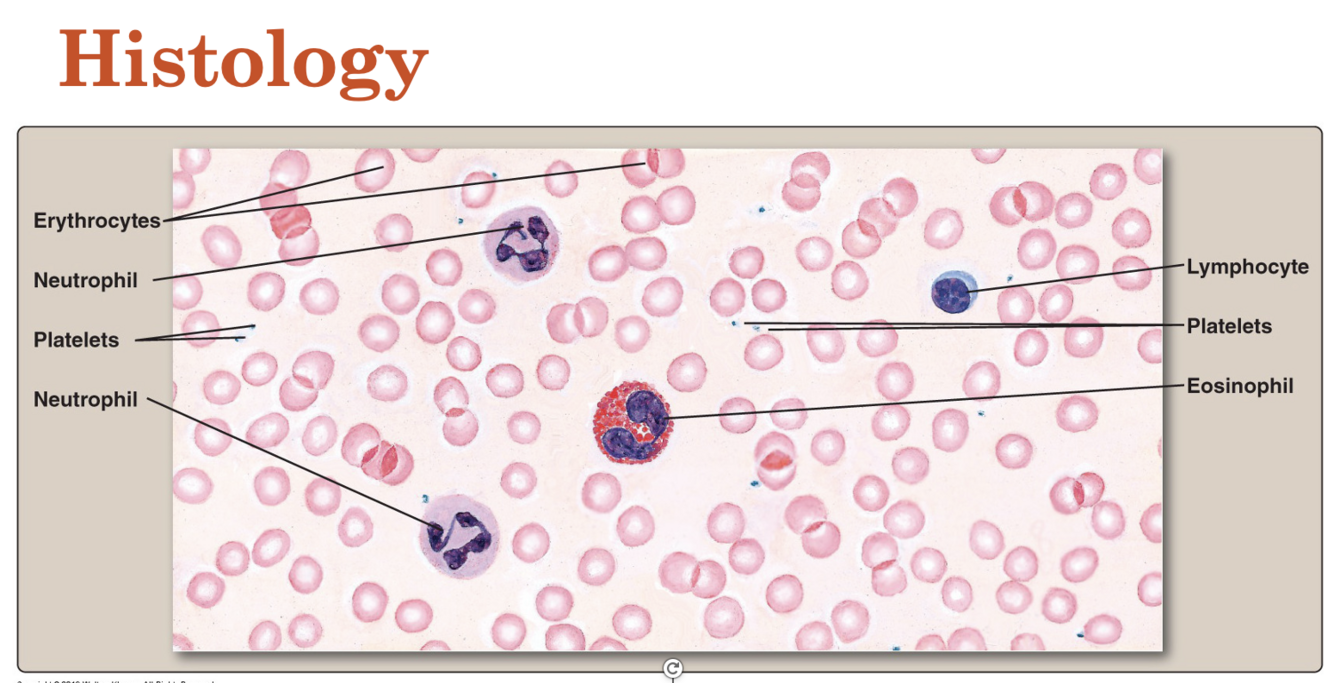
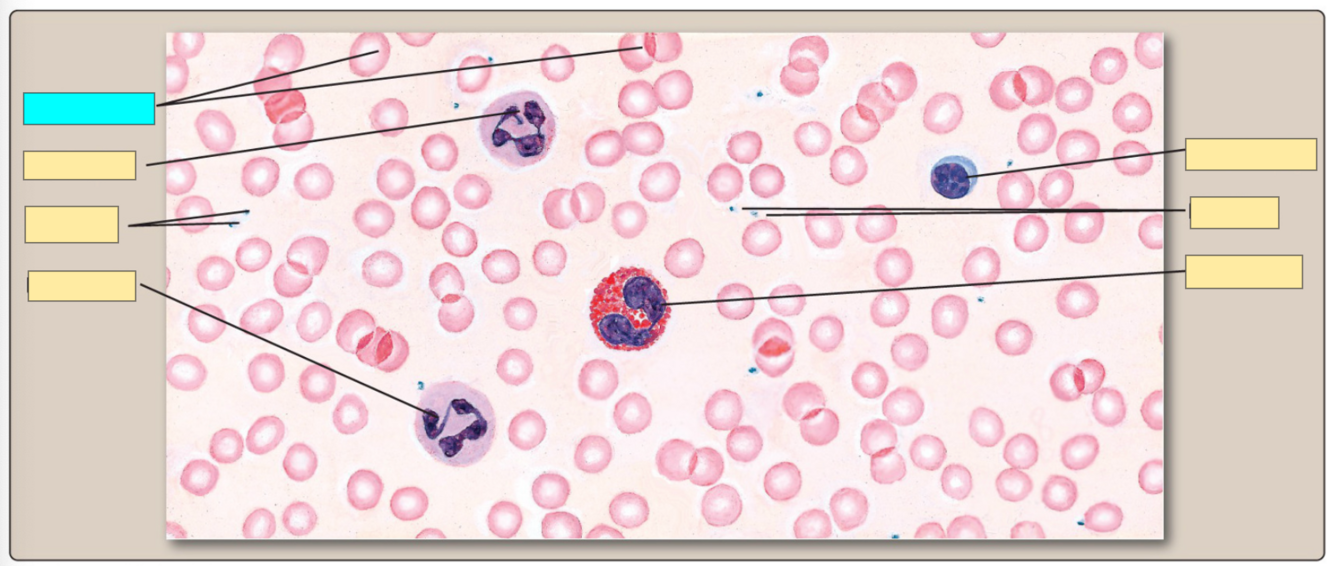
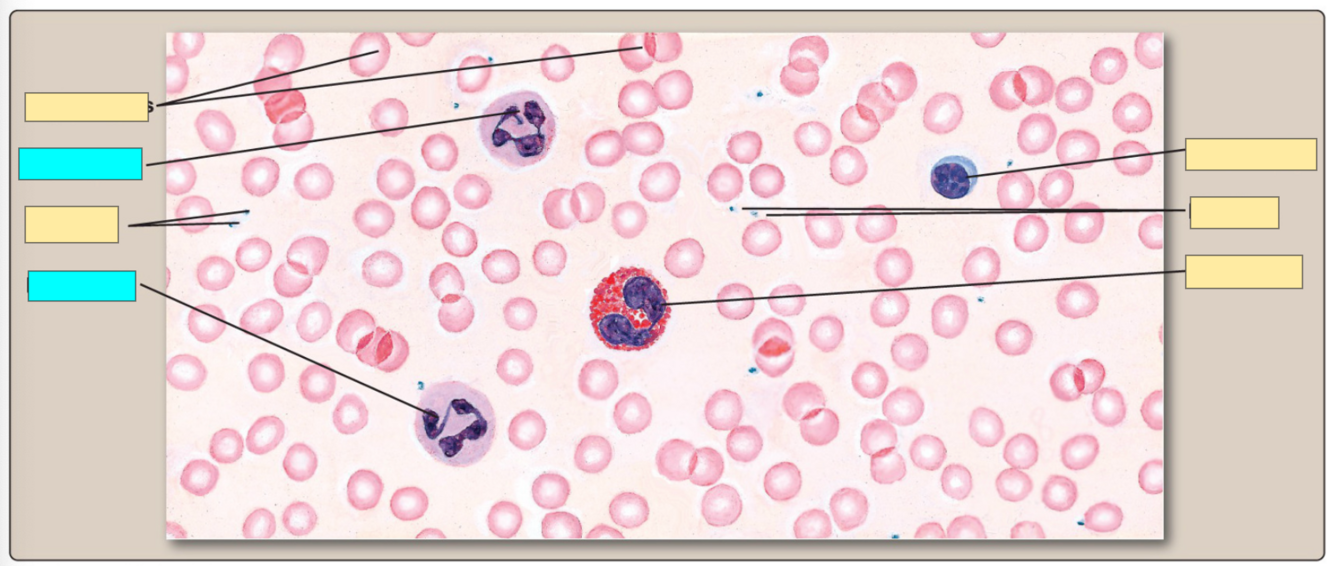
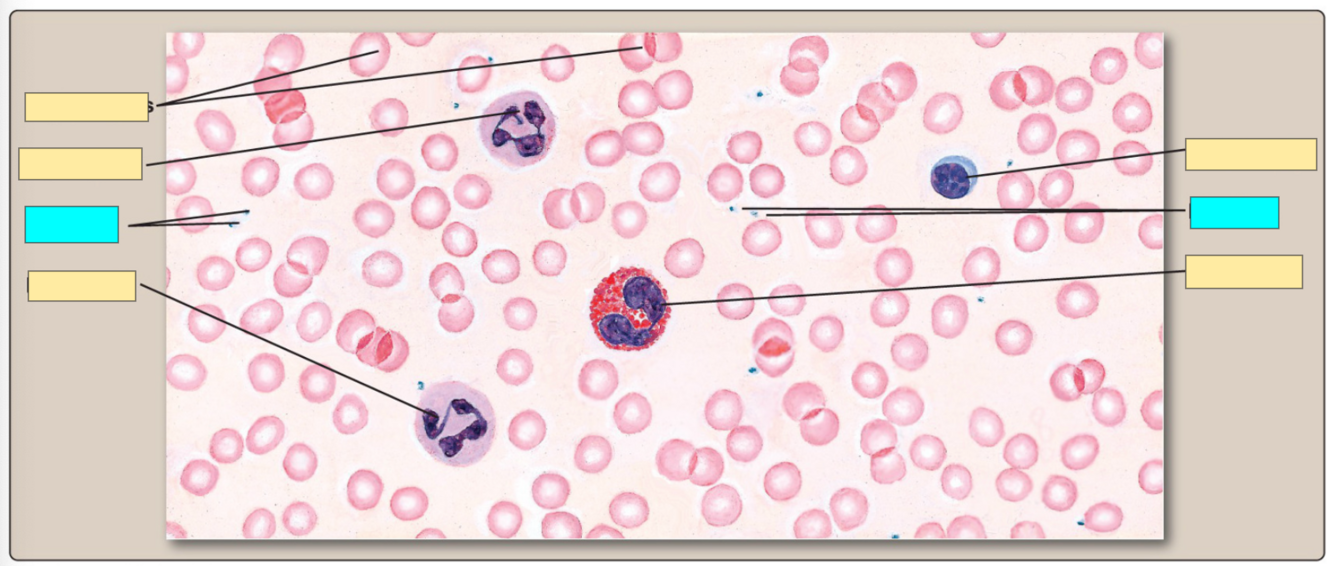
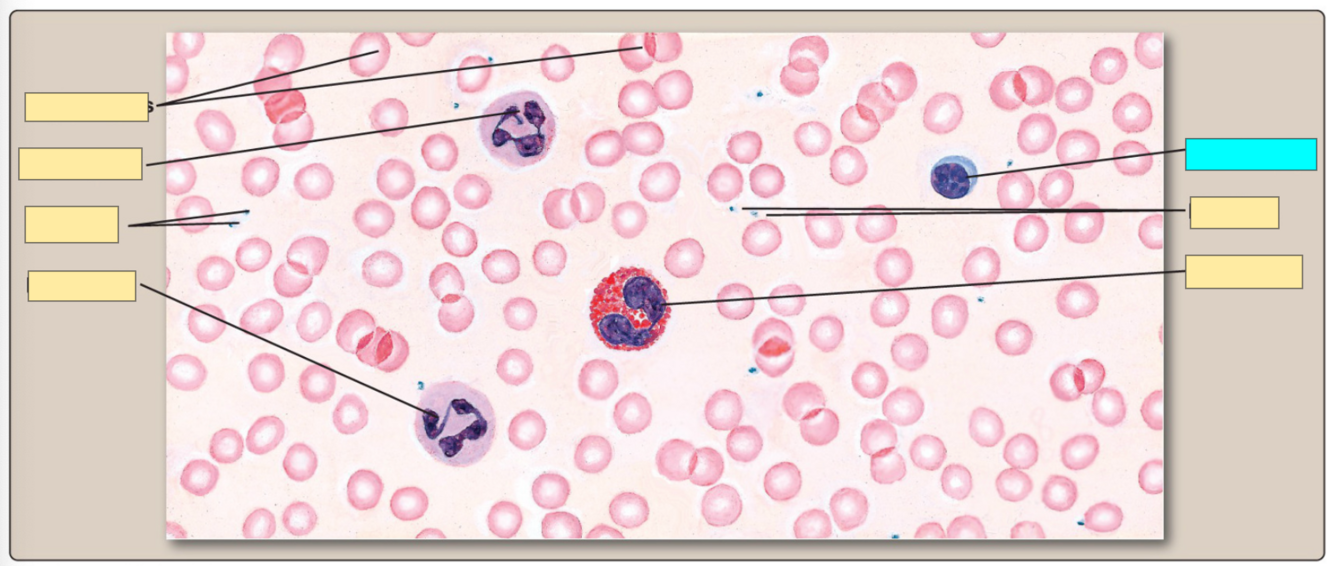
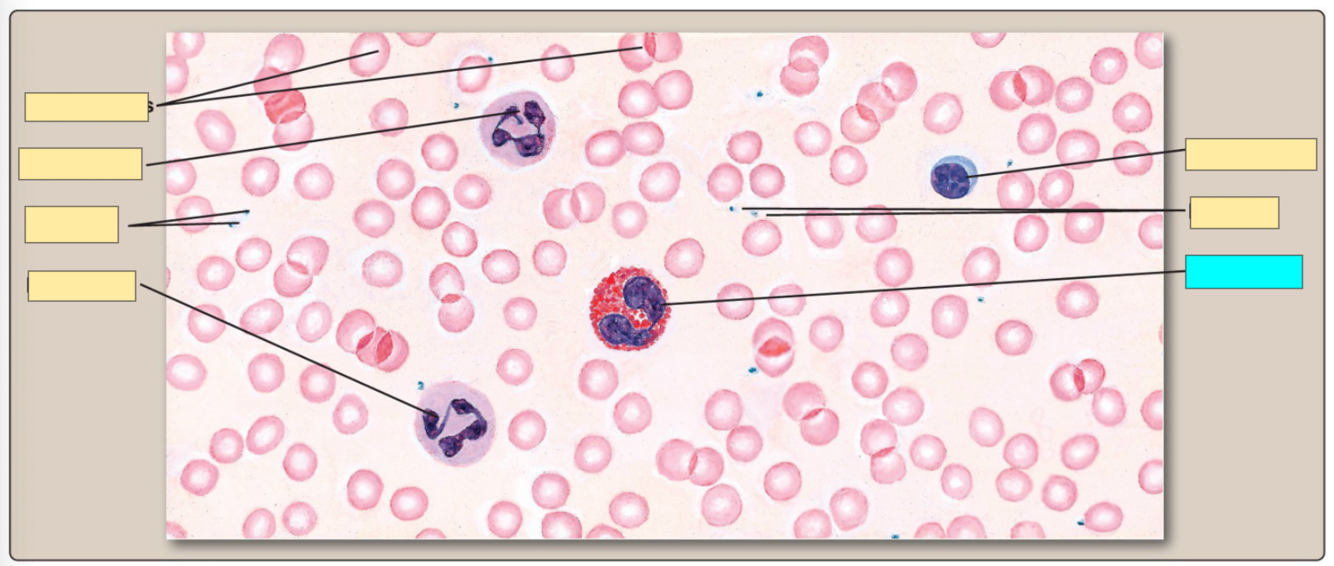

A specialized connective tissue, has cells (erythrocytes, leukocytes) suspended in liquid matrix (plasma) and cells have certain functions = ?
Hematologic System
Blood:
- Is a specialized connective tissue, has cells (erythrocytes, leukocytes) suspended in liquid matrix (plasma) and cells have certain functions.
- About 5 liters of blood continuously circulates in human body.
- 7-8% of the total body weight.
Blood Composition = ?
Hematologic System
Blood Composition:
(a) Plasma (55%)
Proteins (7%)
- Albumin (54%) = Protein in the blood plasma that helps keep fluid from leaking out of blood vessels into other tissues.
- Fibrinogen (7%) = Protein produced by the liver that helps stop bleeding by helping blood clots form.
- Globulins (38%) = Group of proteins in the blood that are important for liver function, blood clotting, and fighting infection.
- Others (1%)
(b) Water (91.5%)
(c) Other solutes (2%)
- Electrolytes
- Hormones, enzymes
- Nutrients, carbohydrates, fats
- Gases
- Waste products
(d) Red blood cells: 4.8-5.4 billion /ul
(e) Platelets: 150,000-400,000 /ul
(f) White blood cells: 5,000-10,000 /ul
- Neutrophils (60-70%)
- Lymphocytes (20-25%)
- Monocytes (3-8%)
- Eosinophils (2-4%)
- Basophils (0.5-1%)

Fuction of plasma = ?
Hematologic System
Plasma:
- As a transport vehicles for nutrients, chemical messengers, metabolites.
- Maintain electrolytes and acid/ base balance.
Function of plasma proteins:
- Albumin= ?
- Globulins = ?
- Fibrinogen = ?
Hematologic System
Function of Plasma Proteins:
Albumin:
- Maintains plasma oncotic pressure and maintain blood volume.
- Serves as a carrier.
Globulins:
- Alpha - transports bilirubin
- Beta - transports iron
- Gamma - antibodies of immune system
Fibrinogen:
- Helps form fibrin for blood clotting.
- Prothrombin (II) - Thrombin (IIa) - Fibrinogen - Fibrin
- Albumin: A protein in the blood plasma that helps keep fluids from leaking out of blood vessels and into other tissues.
Serum = ?

Hematologic System
Serum = Plasma - Fibrinogen

Small, biconcave disk, diameter 6-8micro meter, high elasticity (easily deform into any shape = ?
Hematologic System
Red Blood Cells (RBCs):
- Small, biconcave disk, diameter 6-8micro meter, high elasticity (easily deform into any shape.
Histology Identification
?
Hematologic System
Erythrocytes:
- Red blood cells (RBCs), are one of the major types of blood cells found in vertebrates.
- Primarily responsible for carrying oxygen from the lungs to the body’s tissues and transporting carbon dioxide from the tissues back to the lungs for exhalation.

Histology Identification
?
Hematologic System
Neutrophil:
- The most abundant type of white blood cell in humans and are essential for defending the body against bacterial and fungal infections.
- They are part of the innate immune system, which provides the first line of defense against pathogens.
- Phagocytosis: Neutrophils are highly mobile and capable of migrating to sites of infection or inflammation.

Histology Identification
?
Hematologic System
Platelets:
- Thrombocytes, are small, colorless cell fragments found in the blood.
- They play a crucial role in blood clotting (hemostasis) to prevent excessive bleeding when a blood vessel is injured.
- When a blood vessel is damaged, platelets become activated and adhere to the site of injury, forming a temporary plug to stop bleeding.
- Platelets are produced in the bone marrow.
- They also release chemical signals to attract more platelets and facilitate the formation of a stable blood clot.

Histology Identification
?
Hematologic System
Lymphocytes:
- Lymphocytes are a type of white blood cell (leukocyte) that plays a key role in the body’s immune system.
(I) T lymphocytes (T cells):
- These lymphocytes mature in the thymus gland and play a central role in cell-mediated immunity.
- They are involved in recognizing and destroying infected or abnormal cells, regulating immune responses, and coordinating the immune system’s actions.
(II) B lymphocytes (B cells):
- These lymphocytes mature in the bone marrow. They are responsible for producing antibodies (immunoglobulins), which are proteins that recognize and bind to specific antigens (foreign substances such as viruses or bacteria), marking them for destruction by other immune cells.
- B cells also play a role in the immune memory, providing long-term protection against pathogens.
(III) Natural killer (NK) cells:
- These lymphocytes are part of the innate immune system and are responsible for recognizing and destroying abnormal cells, such as infected or cancerous cells.
- NK cells can directly target and kill these cells without prior sensitization or activation.
?
Hematologic System
Eosinophil:
- Eosinophils are primarily involved in combating parasitic infections and modulating allergic responses.
- Eosinophils are recruited to sites of inflammation or infection by various chemotactic factors, including cytokines, chemokines, and lipid mediators

5 Facts about RBCs = ?
Hematologic System
Red Blood Cells:
- Most common type of blood cell, non nucleated biconcave disk.
- Large surface area, thin membranes.
- Primary function is to transport oxygen to the tissues and transport carbon dioxide out of the tissues for excretion.
- Helps regulate acid / base balance.
- Oxygen poorly soluble in plasma, 95% is carried bound to hemoglobin
- Each molecule of hemoglobin carries 4 molecule of oxygen.
- Production of red blood cells is called as erythropoiesis / hematopoiesis (bone marrow is the primary site).
- Most iron is recycled in the body after release fromdying red blood cells, careful regulation of ironabsorption in small intestine.
- Small amount of iron is lost and needs to be replaced

Mature RBCs have lifespan = ?
Hematologic System
- Mature RBCs have lifespan of 120 days.
Hematocrit = ?
Hematologic System
(a) Hematocrit
- The measure of the proportion of blood that is cellular, expressed as a percentage.
- Polycythemia: High hematocrit
- Height of erythrocyte column / height of whole blood column x 100
- Women = 37-47
- Men = 42-52
- Volume of cells in 100 ml of blood.
- Centrifuge a blood sample, represented as percentage.
(b) Hematopoiesis:
- Production of blood cells.
- Derived from hematopoietic stem cells
(c) Abnormalities:
- Low hematocrit (anemia) may suggest conditions such as iron deficiency, vitamin B12 deficiency, or chronic diseases.
- High hematocrit may be associated with conditions like dehydration, lung diseases, or polycythemia.

Abnormally low number of red blood cells or levels of hemoglobin= ?

Hematologic System
Anemia:
- Abnormally low number of red blood cells or levels of hemoglobin
- Impairs blood oxygen carrying capacity.
- Can cause tissue hypoxia
- Common acquired / inherited disorder of erythrocytes
In adults, anemia is diagnosed:
* Hematocrit <41% in males
* Hematocrit <37% in females
- Hemoglobin: < 13.5 g/dl in males
- Hemoglobin: <12 g/dl in females
Cause:
- Reduction of hemoglobin content
- Presence of abnormal hemoglobin
- Decrease in the number of circulating erythrocytes
- Blood loss (chronic GI blood loss- aspirin/ NSAIDS; GI ulcers, cancers)
- Destruction of erythrocytes
- Inadequate red blood cell production
- Defective red blood cell production
Clinical features of anemia include = ?
Hematologic System
Anemia - Clinical Features:
- Weakness
- Fatigue
- Dyspnea
- Hypoxia of brain tissue - headache, faintness
- Pallor (absence of underlying red tones)
- Tachycardia and palpitations
Severe cases:
- Ventricular hypertrophy and heart failure
- Increase respirator rate
- Diffuse bone pain
Typesof anemia = ?
Hematologic System
Types of Anemia: Red cell characteristics seen in different types of anemia.
- (a) Microcytic and hypochromic red cells, characteristic of iron deficiency anemia.
- (b) Macrocytic and misshaped red blood cells, characteristic of megaloblastic anemia.
- (c) Abnormally shaped red blood cells seen in sickle cell disease.
- (d) Normocytic and normochromic red blood cells, as a comparison.

Occurs when iron is not enough to meet the demands of hemoglobin production or loss of iron through bleeding= ?
Hematologic System
Iron Deficiency Anemia:
- Occurs when iron is not enough to meet the demands of hemoglobin production or loss of iron through bleeding.
(a) Cause:
- Decreased iron consumption.
- Decreasediron absorption.
- Increased bleeding (mensuration,certain cancers)
- Increased iron demand (women ofchild bearingage and pregnant women).
- Iron is stored in transport proteins like ferritin and transferrin.
(b) Notes:
- Iron is needed for hemoglobin production andformation of erythrocytes.
- Common worldwide cause of anemia affecting people of all ages.

Groups at risk for iron deficiency anemia = ?
Hematologic System
Groups at risk:
- Pregnant women
- Women with heavy menstrual bleeding
- Infants and younger children
- Frequent blood donors
- People with cancer, GI diseases/ surgery-who report of chronic blood loss
- Vegetarian diet
- Iron Deficiency Anemia
RDA for iron = ?
Hematologic System
RDA for Iron:

Clinical features - Iron Deficiency Anemia = ?
Hematologic System
Clinical features - Iron Deficiency Anemia:
(a) Mild anemia causes mild and vague symptoms like fatigue.
- Brittle nails with koilonychias (spoon shaped).
- Unusual food cravings (pica; ice, clay, soil, paper).
- Headache
- Irritability
- Delayed healing
- Tachycardia, palpitations
- Decreased appetite
(b) Neurologic impairment:
- Confusion and memory loss; mitochondrial damage
- Neurologic damage (development delays in children).
Diagnosis and treatment of iron deficiency anemia = ?
Hematologic System
Diagnosis and Treatment - Iron Deficiency Anemia:
(a) Diagnosis:
- Low hemoglobin and hematocrit
- CBC (erythrocyte count, hemoglobin levels)
- RBCs microcytic and hypochromic
- Serum ferritin (major iron storage protein in the body)
- Serum iron
(b) Treatment:
- Treating the cause of iron deficiency
- Consuming iron rich foods like liver, red meat, fish, beans, raisins, green leafy vegetables
- Iron supplements, use of iron fortified formulas and cereals for infants
- Foods / supplements with high vitamin C = promotes the absorption of iron.
Megaloblastic Anemia = ?
Hematologic System
Megaloblastic Anemia:
- Caused by impaired DNA synthesis- large immature erythrocytes
(a) Causes:
- B12 deficiency, vitamin B12 (cobalamine) is necessary for DNA synthesis = decreased cell division and cell maturation
- Less B12 absorption (alcohol intake, Crohn’s disease)
- Chronic gastritis, autoimmune destruction of gastric mucosa, gastrectomy
- Folic acid deficiency(rare in US due to supplementation)
- Grains and cereals are supplemented
- Pregnancy increases the requirement- link seen between its deficiency and neural tube defects
- Other causes - alcohol intake, poor diet
Pernicious anemia = ?
Hematologic System
Pernicious anemia:
- specific form of megaloblastic anemia.
- Caused by atrophic gastritis and absence of intrinsic factors - absorption of vitamin B12.







